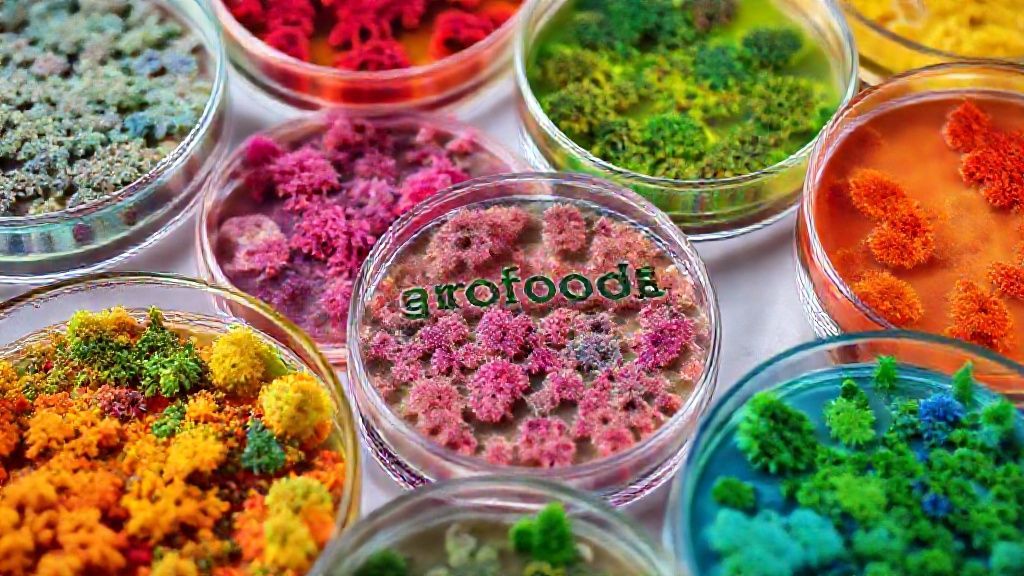
تصویر محیط‌های کشت مختلف در پتری‌دیش

محیط کشت

محیط کشت، بستری حیاتی برای رشد و تکثیر میکروارگانیسمها، نقش بیبدیلی در تضمین کیفیت، سلامت و ایمنی محصولات غذایی ایفا میکند. در زنجیره پیچیده تولید و فرآوری مواد غذایی، از کنترل کیفیت مواد اولیه تا پایش نهایی محصول، این ماده اولیه آزمایشگاهی ستون فقرات ارزیابیهای میکروبیولوژیک است. با این حال، تأمین محیط کشت با کیفیت و استاندارد در بازار ایران، همواره با چالشهایی نظیر نوسانات ارزی، محدودیتهای واردات و اطمینان از اصالت کالا همراه بوده است. این مقاله به واکاوی جامع ابعاد صنعتی و تجاری محیط کشت در صنعت غذا میپردازد تا راهنمای جامعی برای تولیدکنندگان، بازرگانان و تامینکنندگان مواد اولیه آزمایشگاهی باشد.
تعریف تخصصی و نقش حیاتی محیط کشت در صنعت
محیط کشت مخلوطی غنی از مواد مغذی است که شرایط لازم برای رشد انواع باکتریها، قارچها و دیگر میکروارگانیسمها را فراهم میکند. این مواد شامل کربوهیدراتها، پروتئینها، ویتامینها، مواد معدنی و گاهی آنتیبیوتیکهای انتخابی هستند که ترکیب دقیق آنها بسته به نوع میکروارگانیسم هدف متفاوت است.
کاربرد صنعتی محیط کشت گسترده است؛ از شناسایی عوامل بیماریزا در فرآوردههای گوشتی، لبنی و غلات، تا کنترل کیفیت آب آشامیدنی و ارزیابی استانداردهای بهداشتی در خطوط تولید. این ماده ابزاری ضروری برای هر واحد تولیدی است که به سلامت محصول و مصرفکننده اهمیت میدهد.
همچنین، در صنایع تخمیری مانند تولید ماست، پنیر، نان و نوشیدنیها، محیط کشت برای فعالسازی و نگهداری سویههای آغازگر (استارتر کالچر) استفاده میشود. این امر به کنترل دقیق فرآیندهای بیولوژیکی و حفظ کیفیت نهایی محصول کمک شایانی میکند.
راهنمای جامع خرید عمده و بهترین گریدها
برای خرید عمده مواد اولیه صنایع غذایی، بهویژه محیط کشت، آگاهی از تفاوت گریدها (درجهبندیهای کیفی) حیاتی است. محیطهای کشت به طور کلی در دو گرید اصلی عرضه میشوند: گرید آزمایشگاهی (Laboratory Grade) و گرید صنعتی (Industrial Grade)، هرچند که ممکن است زیردستههای تخصصیتری نیز داشته باشند.
گرید آزمایشگاهی معمولاً خلوص بالاتری داشته و برای تحقیقات دقیق و حساس مناسب است. اما گرید صنعتی که اغلب برای حجمهای بالاتر و کاربردهای روتین کنترل کیفیت در کارخانجات استفاده میشود، باید همچنان از استانداردهای کیفی مشخصی برخوردار باشد. انتخاب گرید صحیح بستگی به حساسیت آزمون و نوع محصول نهایی دارد.
نکات کلیدی برای تضمین کیفیت و خرید موفق شامل بررسی گواهینامههای آنالیز محصول (COA)، تاریخ انقضا و شرایط نگهداری توصیه شده توسط تامینکننده است. همچنین، خرید از منابع معتبر و دارای سابقه درخشان در تامین تجهیزات آزمایشگاهی صنایع غذایی، ریسک خرید محصولات بیکیفیت را به حداقل میرساند.
آنالیز قیمت روز محیط کشت و عوامل موثر بر آن
قیمت روز محیط کشت به عوامل متعددی وابسته است که درک آنها برای بازرگانان و تولیدکنندگان ضروری است. یکی از مهمترین متغیرها، نوسانات نرخ ارز است، چرا که بخش قابل توجهی از محیطهای کشت تخصصی از طریق واردات تامین میشوند.
تولید داخلی محیط کشت، در صورت وجود و توسعه، میتواند به ثبات بیشتر قیمتها کمک کند. با این حال، هزینههای مواد اولیه مورد نیاز برای تولید داخلی، تکنولوژی ساخت و استانداردهای کیفی نیز بر قیمت نهایی تاثیرگذارند. فصول سال و تقاضای بازار نیز میتوانند بر عرضه و قیمت روز مواد اولیه آزمایشگاهی تاثیر بگذارند.
علاوه بر این، برند تولیدکننده (داخلی یا خارجی)، حجم خرید (عمده یا خرد)، هزینههای حمل و نقل و بستهبندی نیز بر قیمت تاثیر مستقیم دارند. انجام آنالیز کیفیت و مقایسه قیمتها از چندین تامینکننده، برای دستیابی به بهترین معامله ضروری است.
چالشهای تأمین و انتخاب تامینکننده معتبر در بازار ایران
تأمین محیط کشت در بازار ایران با چالشهای خاص خود همراه است. مهمترین آنها شامل: ثبات کیفی محصول در طول زمان، اطمینان از اصالت کالا و جلوگیری از ورود محصولات تقلبی یا تاریخگذشته، و تحویل به موقع سفارشها به خصوص برای محصولات با ماندگاری محدود.
انتخاب یک شریک تجاری قابل اعتماد و معتبر برای تامین این ماده حیاتی، نیازمند دقت و بررسی همهجانبه است. معیارهای اصلی برای انتخاب تامینکننده شامل سابقه فعالیت در بازار، دارا بودن گواهینامههای معتبر (مانند ایزو)، ارائه مشاوره فنی، و خدمات پس از فروش است.
شفافیت در ارائه اطلاعات محصول، بهویژه مشخصات فنی و گواهینامههای کیفیت، از دیگر نکات مهم است. همچنین، امکان بررسی نمونههای اولیه و تطابق آن با نیازهای آزمایشگاهی، میتواند در تصمیمگیری نهایی بسیار موثر باشد.
استانداردهای ملی و بینالمللی کیفی محیط کشت
رعایت استانداردها در تولید و تامین محیط کشت امری حیاتی است. در ایران، سازمان ملی استاندارد ایران (ISIRI) نقش محوری در تدوین و نظارت بر استانداردهای کیفی این محصولات ایفا میکند. استاندارد ملی ایران به شمارههای خاصی برای انواع مختلف محیطهای کشت میکروبیولوژیک وجود دارد که باید مد نظر قرار گیرند.
در سطح بینالمللی، استانداردهایی نظیر ISO (سازمان بینالمللی استانداردسازی) و CLSI (موسسه استانداردهای آزمایشگاهی و بالینی) برای روشهای آزمون میکروبی و کیفیت محیطهای کشت تعریف شدهاند. خریداران باید در گواهیهای آنالیز محصول (COA) و برچسبگذاری، به این استانداردها دقت کنند.
این استانداردها شامل پارامترهایی نظیر pH، قدرت رشد (Growth Promotion)، خلوص میکروبی، و خواص انتخابی محیط (در صورت وجود) هستند. اطمینان از تطابق محصول با این معیارها، تضمینکننده نتایج دقیق و قابل اعتماد در آزمایشات است.
روشهای نگهداری و انبارداری صحیح محیط کشت
نگهداری و انبارداری صحیح محیط کشت برای حفظ کیفیت و جلوگیری از افت کارایی آن اهمیت فراوانی دارد. اکثر محیطهای کشت، بهویژه آنهایی که به صورت پودری یا گرانول عرضه میشوند، باید در محیط خشک و خنک نگهداری شوند.
دمای مناسب نگهداری معمولاً بین 2 تا 8 درجه سانتیگراد یا دمای اتاق (20 تا 25 درجه سانتیگراد) است که باید طبق دستورالعمل تولیدکننده رعایت شود. رطوبت محیط نیز نباید بالا باشد، زیرا میتواند منجر به جذب رطوبت توسط پودر و کلوخه شدن آن شود که کیفیت محیط را به شدت تحت تأثیر قرار میدهد.
دور از نور مستقیم خورشید و منابع حرارتی قرار دادن محیط کشت نیز از اهمیت بالایی برخوردار است. همچنین، پس از هر بار استفاده، بستهبندی باید به دقت و محکم بسته شود تا از آلودگی و جذب رطوبت جلوگیری به عمل آید. رعایت این نکات، ماندگاری و پایداری محیط کشت را تضمین میکند.
مقایسه واردات و تولید داخلی: کدام انتخاب منطقیتر است؟
تصمیمگیری بین واردات و تکیه بر تولید داخلی محیط کشت، یکی از چالشهای اساسی برای فعالان صنعت غذا در ایران است. هر دو رویکرد مزایا و معایب خاص خود را دارند که باید با دقت بررسی شوند.
مزیت اصلی واردات، دسترسی به طیف وسیعتری از محصولات با برندهای معتبر جهانی و گاهی تکنولوژیهای پیشرفتهتر است. این امر میتواند منجر به انتخابهای دقیقتر و مناسبتر برای نیازهای خاص آزمایشگاهی شود. با این حال، نوسانات نرخ ارز، محدودیتهای گمرکی و زمانبر بودن فرآیند واردات، از معایب عمده آن محسوب میشود.
از سوی دیگر، حمایت از تولید داخلی میتواند به پایداری تأمین، کاهش وابستگی به خارج، و ثبات نسبی قیمت روز محیط کشت کمک کند. در صورتیکه تولیدکنندگان داخلی بتوانند استانداردهای کیفی جهانی را رعایت کرده و تنوع محصولی کافی ارائه دهند، انتخاب منطقیتری خواهد بود. اما اگر کیفیت یا تنوع محصول داخلی کافی نباشد، تامینکنندگان ممکن است ناچار به واردات باشند.
برای تصمیمگیری هوشمندانه، لازم است تا آنالیز کیفیت دقیق و مقایسه جامع بین محصولات داخلی و وارداتی صورت گیرد. همچنین، ارزیابی پایداری تامین و خدمات پس از فروش هر دو گزینه نیز از اهمیت بالایی برخوردار است.
جمعبندی و فراخوان به اقدام
محیط کشت، فراتر از یک ماده آزمایشگاهی، ستون فقرات ایمنی و کیفیت در صنعت غذا محسوب میشود. انتخاب و تأمین صحیح این ماده، تأثیری مستقیم بر اعتبار و سلامت محصولات تولیدی شما خواهد داشت. در بازاری پویا و پرچالش مانند ایران، تصمیمگیری هوشمندانه در خصوص خرید عمده، انتخاب گرید مناسب، شناخت عوامل موثر بر قیمت و تشخیص تامینکننده معتبر، رمز موفقیت است.
اطلاع از استانداردهای ملی و بینالمللی، درک تفاوتهای واردات و تولید داخلی و رعایت دقیق روشهای نگهداری، همگی به شما کمک میکنند تا از سرمایهگذاری خود نهایت بهره را ببرید. برای یافتن تامینکنندگان معتبر و مشاهده آگهیهای تخصصی در مورد محیط کشت همین حالا در اگروفودز جستجو یا آگهی ثبت کنید.

